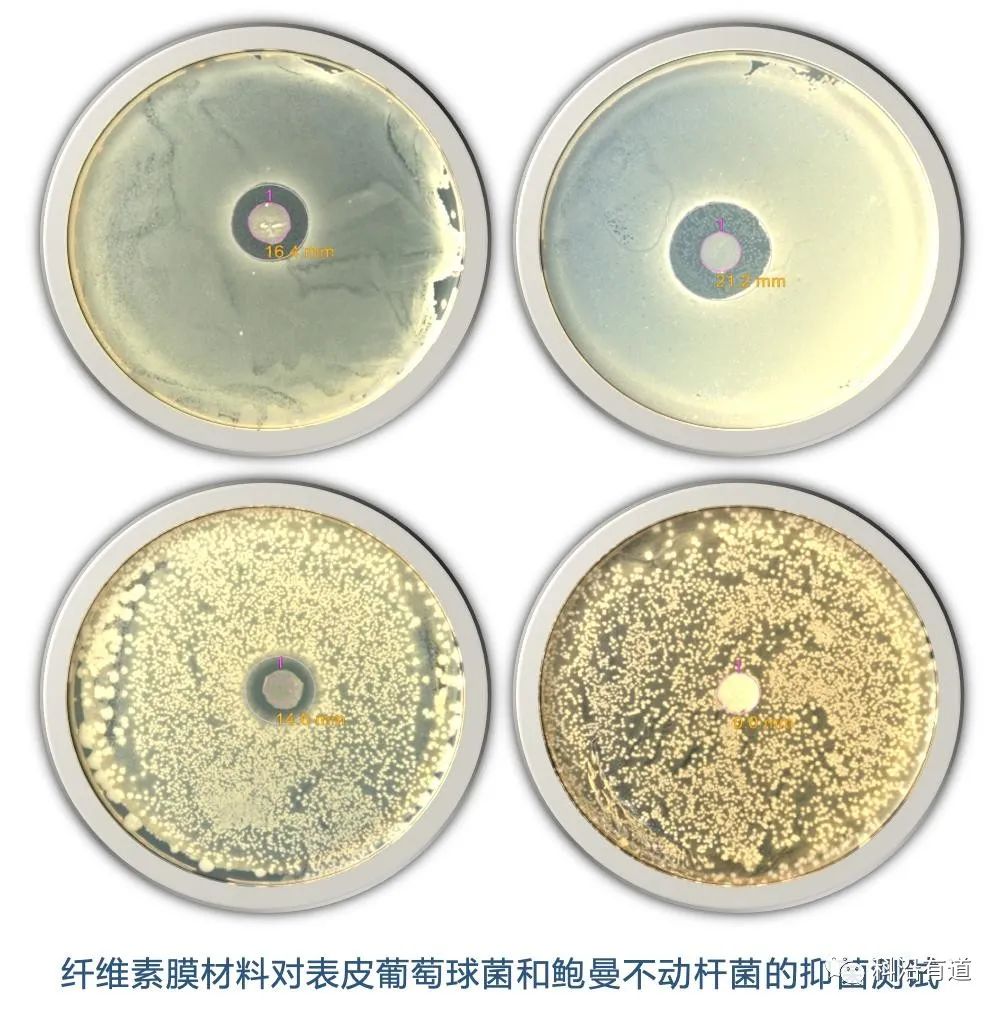
图片
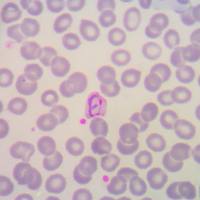
CHO细胞表达

万千商家帮你免费找货
0 人在求购买到急需产品
- 详细信息
- 文献和实验
- 技术资料
一、背景介绍
抑菌实验通常被用于检测各类药物、抗菌肽、抗菌材料等的抑菌效果检测,其应用遍布医学、食品、工业、农业等各个领域。 科沿有道生物以严谨的实验设计和操作,运用进口全自动影像分析菌落计数仪进行数据分析,为客户提供客观严谨的抑菌实验结果。二、材料类抑菌实验常见方法
1) 抑菌圈法
先制备含菌平板,然后在平板上放置抑菌材料,培养后观察材料周围细菌的生长情况,根据各洞抑菌圈的大小来判断药物对该菌的抑菌能力。2) 活菌计数法
采用液体培养法,材料与测试细菌共培养后,测定OD600,根据OD值选择合适稀释梯度进行平板涂布,计数活菌数量,根据平板中的菌落数量,与对照组比较后,获得抑菌率结果。三、案例展示
风险提示:丁香通仅作为第三方平台,为商家信息发布提供平台空间。用户咨询产品时请注意保护个人信息及财产安全,合理判断,谨慎选购商品,商家和用户对交易行为负责。对于医疗器械类产品,请先查证核实企业经营资质和医疗器械产品注册证情况。
 文献和实验
文献和实验远古化石提示花之起源!中科院史恭乐等 Nature 重磅报道被子植物起源
、Petriellaea、Reymanownaea、Umkomasia 等属以及其他盔籽类植物的壳斗结构与现生被子植物的外珠被可能属于同源结构,并由此解释了被子植物外珠被的起源问题。 注:珠被(integument)是指胚珠中包裹在珠心组织外面的细胞层。不同于拥有单层珠被的裸子植物,绝大多数被子植物的胚珠拥有内外两层珠被。其中外珠被是被子植物胚珠特有的结构,它在遗传起源上与内珠被完全不同。因此,解决外珠被的起源问题对于解决被子植物起源问题有重要意义。研究内容1. 化石形态描述这些保存完好的化石材料发掘自中国内蒙古东部
,自己的师兄师姐在做关于纳米载药的靶向治疗的研究。这篇文章会不会提供很好的 idea?《Advanced Materials》还会涉及很多 3D 打印、纳米材料、仿生材料等等和我们专业研究相近的东西,看别人的顶尖研究成果,自己大脑中总是刷起无数个 666...接着是第 2 类,及查找资料类。举个栗子,我想做 microRNA、long no coding RNA(lncRNA)、或者是某类生理现象其内部的通路表达、基因表达等等等,但是呢,上述东西我都不是很了解,自己的实验还要涉及这些,躲也躲不开。别担心
失去兴趣。虽然最终他们也能懂,但是对他们来说,读 起来就很费劲。我老板改的,就完全符合英文读者的阅读习惯。 所以有人说,你看一篇英文文章,如果读起来特别顺口的话,往往它是中国人写的,因为我们对 the stress position 有相同的习惯。知道了上面组织英文句子的原则,写起来就可以把句子搞的紧凑一点。 还有一个问题是,有时候我们不能完全做到每次都用旧信息带入新信息,那怎么办呢?那就要借助连词的作用了。这一点,中英文差别倒不是很大。 比如:A 类材料中会有性质 B。B 很普遍,可以用理论 C
 技术资料
技术资料暂无技术资料 索取技术资料